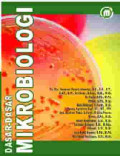
cover

Dasar - Dasar Mikrobiologi
- Edisi
- -
- ISBN/ISSN
- 978-602-71107-5-5
- Deskripsi Fisik
- -
- Judul Seri
- -
- No. Panggil
- -
- Edisi
- -
- ISBN/ISSN
- 978-602-71107-5-5
- Deskripsi Fisik
- -
- Judul Seri
- -
- No. Panggil
- -
Kimia Organik
- Edisi
- -
- ISBN/ISSN
- 978-623-459-376-1
- Deskripsi Fisik
- -
- Judul Seri
- -
- No. Panggil
- -
- Edisi
- -
- ISBN/ISSN
- 978-623-459-376-1
- Deskripsi Fisik
- -
- Judul Seri
- -
- No. Panggil
- -
Hasil Pencarian
Ditemukan 2 dari pencarian Anda melalui kata kunci: Pengarang : Dessy Agustina Sari
Permintaan membutuhkan 0.00092 detik untuk selesai

Karya Umum
Karya Umum  Filsafat
Filsafat  Agama
Agama  Ilmu-ilmu Sosial
Ilmu-ilmu Sosial  Bahasa
Bahasa  Ilmu-ilmu Murni
Ilmu-ilmu Murni  Ilmu-ilmu Terapan
Ilmu-ilmu Terapan  Kesenian, Hiburan, dan Olahraga
Kesenian, Hiburan, dan Olahraga  Kesusastraan
Kesusastraan  Geografi dan Sejarah
Geografi dan Sejarah